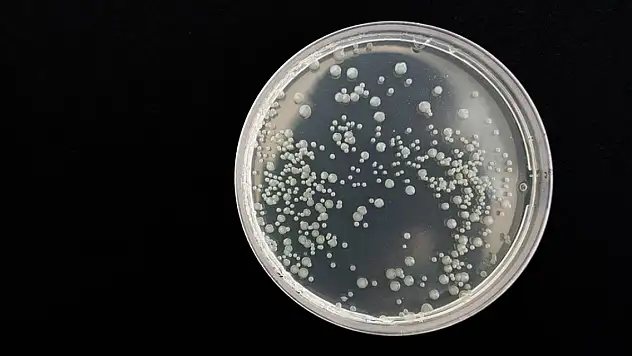
Bilimsel araştırma... Bazı ölümcül bakteriler vampir gibi besleniyor

Sağlık
Güncel sağlık haberi

Hastanelerde "Onaylı Randevu" dönemi başladı

10 soruda hastanede "onaylı randevu" dönemi

Sağlıkta "Onaylı Randevu Dönemi" başlıyor

Vatandaşlara maske uyarısı!

Yüksek numaralı ya da gözü lazer için uygun olmayan hastalara alternatif çözümler

Çöl tozlarıyla birlikte bu şikayetlerde artış yaşandı

Kovid-19'un DNA dizilimini açıklayan bilim insanının, laboratuvarına dönmesine izin verildi

5 bin yıllık tedavi... Hastalara şifa dağıtıyor

Zerdeçalın hiç bilmediğiniz faydaları

İtalyan profesör Aiuti, Konya'da SMA hastalığında gen tedavisini anlattı

Sahte güneş gözlüğünde büyük tehlike

36 bin sağlık personeli istihdam edilecek! Kadro dağılımı belli oldu

Yalova İl Sağlık Müdürlüğü'nden açıklama!

Yapay zekayla hastaneler hastaların ayağına gelecek

Havalar ısındı, yılın ilk kene vakası görüldü

Konyalı ve Erzincanlı harcalar çapraz nakille 'can kardeşi' oldular

Sedef hastalığında beslenmenin önemi!

Her şeyin başı beyin!
Bilimsel araştırma... Bazı ölümcül bakteriler vampir gibi besleniyor

Hastaneden ikinci kez randevu alıp gitmeyenlere yeni kısıtlama geliyor!

Mevsimsel polen alerjisine dikkat!

Düzenli Diş Bakımının Önemi

Türkiye'deki meşhur soda markası için 'sakın içmeyin' uyarısı

Tırnak yemenin asıl sebebi bakın neymiş! Şok gerçekler

Güneş gözlüğü alırken bu ayrıntıya dikkat! Gözünüzden olmayın

Ramazan sonrası duyulan yemek ihtiyacına dikkat

Nuri Alço'dan yeni haber

Yeni doğan 14 bin bebek korkutan açıkla! Bu belirtiler varsa dikkat!

Teknoloji gelişti, protezlerin konforu arttı

Kadir İnanır'ın rahatsızlığı 'inme', dünyada sakatlıkların 1'inci, ölümlerin ise 3'üncü sebebi

Ormanda yaralanan vatandaş için ekipler seferber oldu

Vücudunuzdaki ağrıların sebepleri duygusal olabilir!

Ramazanda kilo almamak için bunları yapın!

Sahurda bu besinlerden uzak durun!

Kadınlarda bu hastalık vakalarında artış yaşanıyor... Sebebi ise...

Bu yöntemle saçınıza asla beyaz uğramayacak

Diyetisyenden tavsiye... Sadece ramazanda değil her zaman tüketin!

Ramazan ayında nasıl beslenmeliyiz? Uzmanından tavsiyeler

Sahurdan hemen sonra sakın yatmayın!

Enginarın sırrını çözmek için araştırma tarlası oluşturdu











